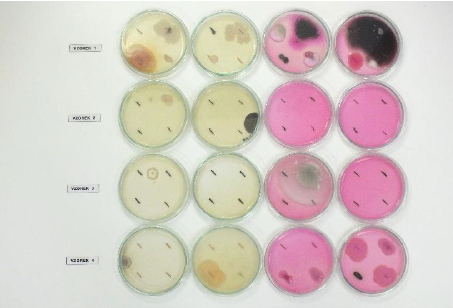

DOPLŇKOVÉ ZKOUŠKY STŘECH: Jak ověřit kvalitu hydroizolace a kdy sáhnout po správné metodě?
V TOMTO ČLÁNKU SE DOZVÍTE:
V čem se liší doplňkové metody od klasické přístrojové defektoskopie
Jak doplňkové metody efektivně rozšiřují možnosti hlavní přístrojové defektoskopie
Klíč k výběru správné kombinace metod pro objektivní vyhodnocení stavu konstrukce
Dokončení ploché střechy nepředstavuje automaticky záruku její kvality. Hydroizolační povlak může skrývat drobné defekty (mikrotrhliny, nedostatečně provedené svary atd.) které nejsou viditelné pouhým okem.
Časem ale způsobí zatékání s fatálními důsledky pro interiér i samotnou konstrukci. Právě proto existuje celá řada zkušebních metod, které pomáhají stav střechy ověřit ještě před předáním díla.

Proč "doplňkové" a v čem se liší od defektoskopie?
Jádrem moderní diagnostiky plochých střech jsou přístrojové metody defektoskopie: elektromagnetická zkouška, jiskrová zkouška, elektroimpulzní nebo impedanční zkouška a metody fungující na principu vhánění plynu do skladby střechy. Tyto technologie dokážou při správném použití spolehlivě a rychle lokalizovat netěsnosti přímo v ploše hydroizolace a v místech jejich ukončení. Výsledkem je přesné označení místa na střeše, fotodokumentace a protokol sloužící jako podklad pro opravu.
Zkoušky popsané v tomto článku jsou označovány jako doplňkové právě proto, že přístrojovou lokalizaci buď předcházejí, doplňují, nebo nahrazují v situacích, kdy ji technicky nelze provést. Zatímco defektoskopické metody jsou zpravidla nedestruktivní a vysoce přesné, doplňkové zkoušky jsou spíše ověřovací a průběžné – zaměřují se na kontrolu spojů při realizaci, celkovou těsnost střechy po dokončení nebo stav jednotlivých materiálových vlastností souvrství.
Vizuální prohlídka, která kontrolu vždy zahajuje, dokáže posoudit tvar svarů, způsob zaválečkování spojů a viditelná poškození v ploše fólie. Sama o sobě však neodhalí skryté vady – proto je nutné ji doplnit.
Přehled doplňkových zkoušek a jejich použití
Jehlová zkouška je základní metodou průběžné kontroly prováděnou přímo pracovníky realizační firmy nebo následně firmy provádějící kontrolu. Spočívá v tažení kovového hrotu zkušební jehly podél svařené hrany fóliového spoje – ověřuje se tak spojitost a mechanická pevnost svaru. Zkouška se provádí až po vychladnutí spoje, zpravidla 15 až 60 minut po jeho dokončení. Za nevyhovující se považuje místo, kde hrot jehly vnikne do spoje zcela nebo i částečně; tato místa se musí opravit navařením záplaty nebo jiným dohodnutým způsobem.
U asfaltových pásů slouží k obdobnému účelu zkouška špachtlí, která se provádí při teplotě pásu v rozmezí 10 °C až 20 °C.
Kdy použít: Ihned po svařování jako průběžná kontrola kvality. Je rychlá, nevyžaduje žádné speciální vybavení a umožňuje okamžitou opravu na místě.
Omezení: Odhalí pouze vady ve spojích, nikoliv poškození v ploše fólie.


Vakuová zkouška je spolehlivou metodou pro ověření těsnosti jednoduchých svarů fóliových hydroizolací. Provádí se dle metodiky ČSN EN 1593 – Nedestruktivní zkoušení – Zkoušení těsnosti – Bublinková metoda. Spoj se nejprve zbaví prachu a nečistot a zvlhčí mýdlovým roztokem (nesmí být těkavý, nesmí zasychat ani příliš pěnit při podtlaku), poté se přiloží průhledný vakuový zvon s vakuometrem napojený na vývěvu. Ta vytvoří podtlak –0,02 MPa (případně –0,05 MPa). Tato hodnota by měla být po dobu 10 sekund konstantní – případná netěsnost se projeví tvorbou vzduchových bublinek.
Kdy použít: Při přejímce díla jako namátková kontrola vybraných spojů, zejména u jednoduchých svarů na rovných podkladech. Doporučuje se také pro místa, která mohla být poškozena jinými stavebními procesy.
Omezení: Metoda je časově náročná a zkoušku nelze provádět na nerovných podkladech.
Tlaková zkouška umožňuje otestovat celou délku dvoustopého svaru nebo přeplátovaného spoje v jediné operaci. Jeden konec svaru se napojí na přívod stlačeného vzduchu s manometrem, druhý se utěsní. Zkušební tlak se přizpůsobuje teplotě fólie a okolního prostředí. Po přibližně pětiminutové stabilizaci, která je nezbytná pro dotvarování spoje a vyrovnání teploty zkušebního vzduchu s okolím, se po dobu 10 minut sleduje stálost tlaku – pokles o více než 10 % signalizuje netěsnost.
Zkoušku nelze zahájit dříve než hodinu po provedení svaru. Podmínkou je provedení spojů s kontrolním kanálkem (dvoustopý svar svařovacím automatem, nebo přeplátovaný spoj).
Kdy použít: V rámci realizace dvoustopého spoje (např. systém DUALDEK)
Retenční zkouška je metodou určenou ke kontrole těsnosti potrubních systémů
a
odvodňovacích prvků, které jsou součástí střešního pláště a nejsou
běžně vizuálně přístupné. Typicky se jedná o střešní vpusti, svislé
svody a jejich napojení na hydroizolační vrstvu.
Kdy použít: Při přejímce nových střešních systémů, případně jako součást pravidelné kontroly jejich funkčnosti v průběhu životnosti stavby.

Kamerová zkouška využívaná zejména při kontrole odvodňovacích svodů slouží k detailní revizi vnitřního stavu dešťových potrubí. Pomocí speciální inspekční kamery s vysokým rozlišením umožňuje vizuálně ověřit průchodnost a neporušenost systému bez nutnosti jakýchkoliv bouracích prací. Tato metoda dokáže odhalit skryté vady, jako jsou praskliny, netěsné spoje, nánosy nečistot nebo mechanická poškození, která by v budoucnu mohla vést k zatékání do konstrukce objektu či fasády.
Kdy použít: Při řešení poruch (zatékání do interiéru či vlhnutí zdiva) nebo v rámci preventivní kontroly u starších objektů za účelem posouzení míry degradace potrubí.

Metoda zkoušky sváru odlupem se zaměřuje na kontrolu provedení systému – homogenní spoj (svar) jednotlivých pásů dle ČSN EN 12316-2. Dále výtažné zkoušky pak ověřují, jakou silou lze vytáhnout kotevní prvky (hmoždinky, šrouby) z podkladní konstrukce. Výsledky musí prokázat průměrnou výtažnou sílu nejméně 1,2 kN na kotvu (s bezpečnostním koeficientem 3 na požadovanou únosnost 0,4 kN), přičemž každá jednotlivá hodnota by měla přesáhnout 1,0 kN. U hliníkových trapézových plechů tloušťky pod 1 mm nebo u dřevotřískových desek se výtažné zkoušky doporučují vždy, bez ohledu na typ kotvení.
Zkoušky vycházejí z požadavků ETAG 006 a EAD 030351-00-0402 (Systémy mechanicky kotvených pružných střešních hydroizolačních povlaků) a z technických listů výrobců kotevních prvků.
Kdy použít: Při plánované rekonstrukci střešního pláště s mechanickým kotvením v rámci předrealizačního průzkumu, při pochybnostech o únosnosti podkladu, nebo pokud výpočet stanoví nestandardní počet kotevních prvků.

7. Karstenova zkouška (diagnostika nasákavosti materiálů)
Karstenova zkouška pomocí speciální trubice s vodním sloupcem měří nasákavost a kapilární absorpci povrchů – například střešních nátěrů, dlažebních spár nebo fasádních vrstev. Výsledkem je stanovení míry absorpce vody za čas, což umožňuje posoudit stav povrchové úpravy a odhadnout riziko průniku vlhkosti do konstrukce.
Kdy použít: Při hodnocení stavu starších nátěrových hydroizolací, fasád a spárových hmot. Ideálně jako součást stavebně-technického průzkumu před rekonstrukcí střechy nebo jako podklad pro návrh sanačního opatření.

Mykologický průzkum identifikuje přítomnost plísní, hub a biologického znečištění v místě dřevěných prvků nebo na jejím povrchu prostřednictvím odběru vzorků a jejich laboratorní analýzy. Výskyt hub nebo plísní bývá příznakem dlouhodobého zatékání nebo kondenzace vlhkosti v souvrství a může signalizovat rozsáhlejší poruchu ve střešním systému.
Kdy použít: Při podezření na dlouhodobé zatékání, při výskytu nepříjemného zápachu v podstřešním prostoru nebo jako součást komplexního stavebně-technického průzkumu starších objektů před rozhodnutím o rozsahu rekonstrukce.

Zátopová zkouška patří k historicky nejrozšířenějším metodám ověření celkové těsnosti ploché střechy. Střecha se naplní vrstvou vody tak, aby hladina dosahovala v nejvyšším místě zkoušeného sektoru nejméně 20 mm nad úrovní vodorovné hydroizolace. Voda se ponechá působit 48 hodin (v odůvodněných případech 24 hodin) a průběžně se sleduje spodní líc stropní konstrukce pro případné průsaky. Pro usnadnění vizuální identifikace úniku vody se doporučuje obarvení – vhodná jsou potravinářská barviva nebo fluorescenční UV pigment o velikosti 0,5 μm, který prochází i kapilárami a je detekovatelný UV lampou bez zanechání viditelných stop.
Pro zátopové zkoušky plošných konstrukcí (střechy a podlahy) dosud neexistuje v ČR závazná normová úprava. V praxi se proto přihlíží k ČSN 75 0905 – Zkoušky vodotěsnosti vodárenských a kanalizačních nádrží, včetně vzoru protokolu o zkoušce. Provedení zátopové zkoušky by přitom vždy mělo být dohodnuto smluvně ještě před zahájením izolačních prací – ideálně na základě předchozí úspěšné jehlové zkoušky všech svarů.
⚠️ Důležitá upozornění: Před zahájením zkoušky je vždy nezbytné statické posouzení nosné konstrukce. Zátopová zkouška dále neumožňuje přímou lokalizaci místa netěsnosti – indikuje pouze přítomnost defektu v zkoušeném sektoru. Nelze ji provádět za deště, silného větru ani při teplotách dlouhodobě pod +5 °C.
Kdy použít: Jako krajní ověřovací metoda u nových plochých střech s vhodnou skladbou. V případě prokázání netěsnosti je zároveň nutné počítat s rizikem nasáknutí tepelněizolačních vrstev a případnými škodami v interiéru.
Srovnání metod jedním pohledem

Jak vybrat správnou metodu?
Doplňkové metody diagnostiky střech představují nezbytnou součást odborného posouzení střešních konstrukcí. Nejsou určeny k plošnému vyhledávání poruch, ale k detailnímu ověření konkrétních míst, kde je potřeba vyšší míra jistoty.
V kombinaci s nedestruktivními i destruktivními metodami umožňují:
zpřesnit diagnostiku
ověřit kvalitu provedení kritických detailů
minimalizovat riziko skrytých vad
Správně zvolený postup diagnostiky vždy vychází z konkrétního stavu střechy, typu konstrukce a cíle kontroly. Právě vhodná kombinace metod je klíčem k objektivnímu a spolehlivému vyhodnocení.
Pokud potřebujete nejen ověřit těsnost, ale defekt také přesně lokalizovat, jsou metodou volby přístrojové metody defektoskopie.
Nechte diagnostiku střechy na odbornících
Tým Revize Střech je připraven pomoci s výběrem i realizací správné metody – od jehlové a retenční zkoušky přes výtažné testy až po zátopovou zkoušku a mykologický průzkum. Výsledkem je vždy písemný protokol s fotodokumentací a doporučením dalšího postupu.
👉 Prohlédněte si naše doplňkové služby a zjistěte, která metoda je pro váš případ nejvhodnější.
Máte otázku nebo potřebujete poradit? Kontaktujte nás prostřednictvím formuláře na našem webu – rádi navrhneme správný postup pro váš konkrétní případ.
Nejčastější dotazy
K čemu slouží doplňkové metody diagnostiky střech?
Doplňkové metody slouží k detailní kontrole konkrétních míst, jako jsou spoje, detaily nebo odvodňovací prvky. Neprovádí se plošně, ale cíleně tam, kde je potřeba přesnější ověření.
Mohou doplňkové metody nahradit hlavní diagnostiku?
Ne. Tyto metody nenahrazují základní diagnostické postupy (např. elektrické metody), ale pouze je doplňují a zpřesňují jejich výsledky.
Kdy se doplňkové metody nejčastěji používají?
Nejčastěji při:
přejímkách nových střech,
kontrole kvality provedení,
řešení lokálních poruch,
ověřování problematických detailů.
Je jehlová zkouška spolehlivá pro zjištění netěsností?
Jehlová zkouška neověřuje těsnost celé střechy. Slouží pouze ke kontrole kvality svarů a jejich mechanické soudržnosti.
Co dokáže odhalit retenční a kamerová zkouška?
Zkoušky umožňují odhalit netěsnosti v potrubí, vpustích a odvodňovacích systémech, které nejsou jinak vizuálně přístupné.
Kdy je vhodné provést zátopovou zkoušku?
Zátopová zkouška se prováděla historicky zejména před zakrytím střechy (např. u zelených střech nebo před instalací FVE), vždy po ověření statické únosnosti konstrukce.
Zajímá vás víc?
➡️ Vyplňte poptávkový formulář
➡️ Zavolejte nám na +420 703 667 634
➡️ Napište na info@revizestrech.cz
Konzultace je nezávazná a zdarma.
Každý článek vychází z reálných zkušeností z terénu a je psaný tak, aby byl srozumitelný a přínosný i pro laiky. Ať už jste projektant, správce budovy nebo majitel nemovitosti, náš obsah vám pomůže lépe porozumět technickým souvislostem a předcházet problémům.
Pokud chcete dostávat nové články pohodlně e-mailem, můžete se přihlásit k odběru – je to zdarma a zcela nezávazné. Odběr lze kdykoli jedním kliknutím zrušit.